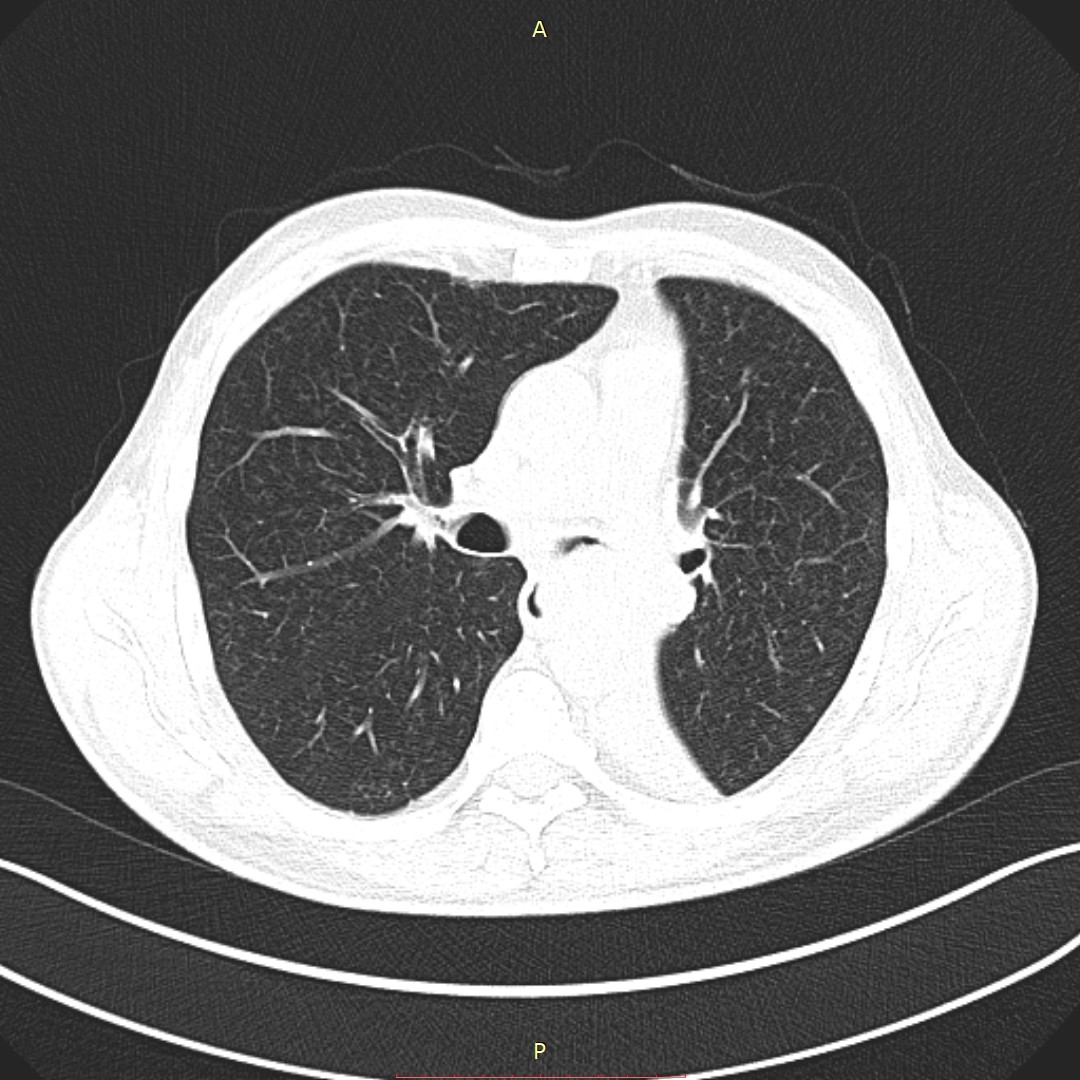

პაციენტი 56 წლის მამაკაცი. მოგვმართა ონკოლოგის რეკომენდაციით ბიოფსიის გასაკეთებლად. გულმკერდის ორგანოების კტ კვლევით ინახა მარცხნივ ფილტვის კარში 35-52მმ ზომის მოცულობითი წარმონაქმნი, რომელიც ახშობს ნაწილობრივ ზედა ხოლო სრულად ქვ/წილოვანი ბრონქების სანათურებს, რაც იწვევს ქვედა წილის ატელექტაზს. ენდობრონქიალური ბიოფსიის მორფოლოგიური გამოკვლევით აღმოჩნდა დაბალდიფერენცირებული, ბრტყელუჯრედოვანი არაგარქოვანებული კიბო G3. ოპერაციული ჩარევა არ ჩაითვალა მიზანშეწონილად. ზოგადი გაუტკივარების პირობებში ჩაიდგა ორი თვითგანშლადი, დაფარული სტენტი, ერთი ქვ/წილოვან, ხოლო მეორე მარცხენა მთავარ ბრონქში. სტენტირების შემდეგ ჩატარებული ბრონქოგრაფიით ინახა თავისუფლად გამავალი როგორც მთავარი, ასევე ქვ/წილოვანი ბრონქები.
- გულმკერდის რენტგენოგრაფია სტენტირებამდე 10 დღით ადრე
- გულმკერდის კტ (Coronal) სტენტირებამდე 5 დღით ადრე
- გულმკერდის კტ (Axial) სტენტირებამდე 5 დღით ადრე
- მარცხენა ქვედა და მთავარი ბრონქების სტენტირება
- გულმკერდის რენტგენოგრაფია სტენტირებიდან 4 დღეში
- გულმკერდის რენტგენოგრაფია სტენტირებიდან 3 თვეში
- გულმკერდის რენტგენოგრაფია სტენტირებიდან 9 თვეში
აღინიშნება მარცხენა ფილტვის სრული ატელექტაზი

აღინიშნება მარცხენა მთავარი ბრონქის ოკლუზია სიმსივნური წარმონაქმნით

პირველი სტენტი მოთავსდა მარცხენა ქვ/წ ბრონქში, მეორე – მარცხენა მთ/ბ.
მარცხენა ფილტვი ნაწილობრივ გაშლილია.
მარცხენა ფილტვი სრულად გაშლილია.

